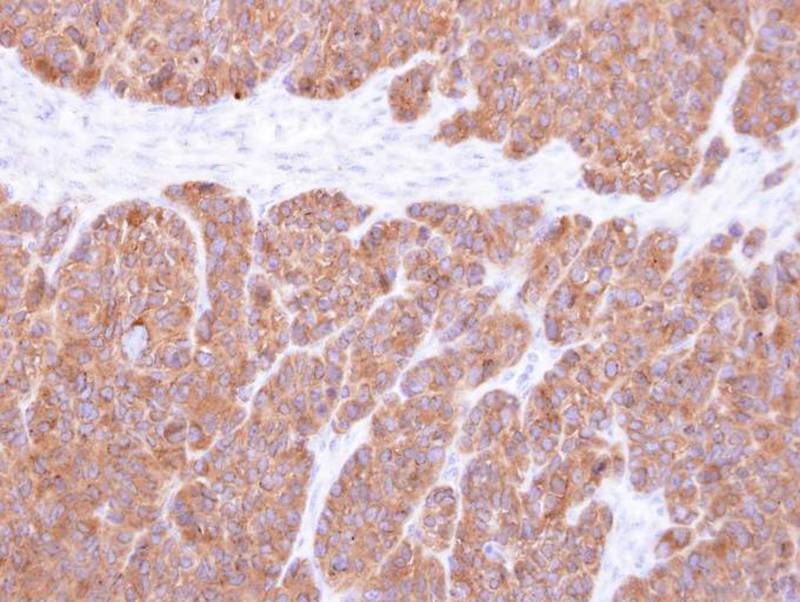
产品细节图片2

相关产品推荐更多 >
万千商家帮你免费找货
0 人在求购买到急需产品
- 详细信息
- 文献和实验
- 技术资料
- 免疫原:
Recombinant protein fragment contain a sequence corresponding to a region within amino acids 1 and 246 of Human VTA1
- 形态:
liquid
- 保存条件:
Store at -20˚C
- 克隆性:
Polyclonal
- 适应物种:
Human
- 保质期:
12 months
- 抗原来源:
Rabbit
- 供应商:
南京赛戈巍生物科技有限公司
- 宿主:
Rabbit
- 应用范围:
WB IHC IF
- 抗体英文名:
Vps20-associated 1 homolog antibody
- 规格:
50ul/100ul
应用详情:Predicted MW: 34kd
Western blotting: 1:500-1:3000
Immunohistochemistry: 1:50-1:500
Immunofluorescence: 1:100-1:200
图片:

Sample(30 ug whole cell lysate)
A: H1299
B: HeLa S3
C: MOLT4
12% SDS PAGE
Primary antibody diluted at 1: 1000
,
Immunohistochemical analysis of paraffin-embedded SW480 xenograft, using VTA1 antibody at 1: 500 dilution.
,

Confocal immunofluorescence analysis (Olympus FV10i) of methanol-fixed A431, using VTA1 antibody (Green) at 1: 500 dilution and alpha-tubulin antibody (Red) at 1: 500.
风险提示:丁香通仅作为第三方平台,为商家信息发布提供平台空间。用户咨询产品时请注意保护个人信息及财产安全,合理判断,谨慎选购商品,商家和用户对交易行为负责。对于医疗器械类产品,请先查证核实企业经营资质和医疗器械产品注册证情况。
文献和实验Epitope Mapping Using Homolog-Scanning Mutagenesis
of antibody-binding sites using serial chimeric proteins of different homologs, a technique termed homolog-scanning mutagenesis (HSM), has proven to be especially useful in mapping conformational epitopes.
secondary antibody review -- data from 99 publications
cytometry used as a control to detect cell responses targeted antigen 7 Alexa Fluor 488 7 Cy3 8 goat IgG Alexa Fluor 488 1:2000 detect antibody binding in human embryonic kidney 293T cells Invitrogen 9 donkey
【翻译】Development trends for monoclonal antibody cancer therapeutics
). However, since 2000, humanized and human mAbs have been entering clinical study at approximately the same rate (4.3 versus 4.5 mAbs per year, respectively). Figure 1 | Categories of monoclonal antibody cancer therapeutics entering clinical study during 1980–1989
技术资料暂无技术资料 索取技术资料





![CD132 Mouse mAb[63242]](https://img1.dxycdn.com/p/s14/2025/0922/632/2321321568067599691.jpg!wh200)
![MC3R antibody[38535]](https://img1.dxycdn.com/p/s14/2025/0922/359/6146153295428599691.jpg!wh200)
![DOR-1 (Phospho-Ser363) Polyclonal Antibody[12298]](https://img1.dxycdn.com/p/s14/2025/0922/568/0046652811090600791.jpg!wh200)
![ICAM1 Polyclonal Antibody HRP Conjugated[C92462HRP]](https://img1.dxycdn.com/p/s14/2025/0922/498/0460884283108299691.jpg!wh200)


